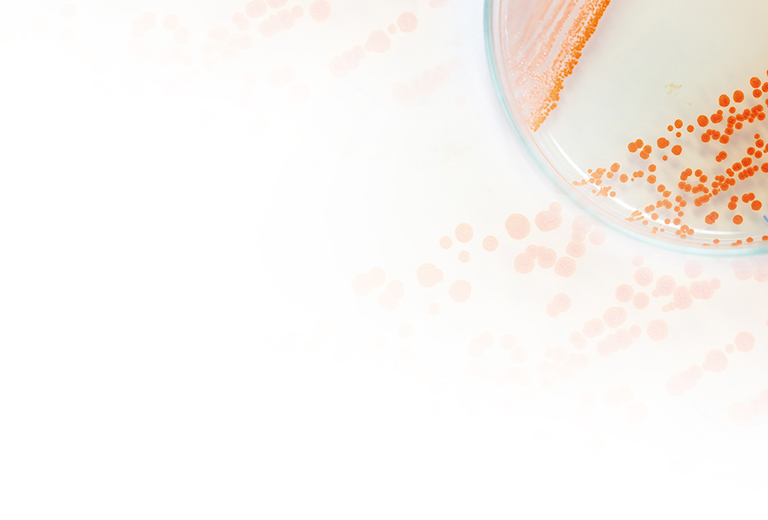
MRGN-Kompetenzzentrum background

MRGN-Kompetenzzentrum
Die Gruppe der multiresistenten gramnegativen Erreger, genannt MRGN, stellt für das Hygienemanagement eine besondere Herausforderung dar. Besondere Bedeutung erlangen „multiresistente gramnegative Stäbchen“ (MRGN) der Gattungen Enterobakterien, Pseudomonas aeruginosa und Acinetobacter baumannii-Komplex. Diese werden vom RKI in Abhängigkeit von der Resistenz gegen die vier wichtigsten Antibiotikaklassen und der klinischen Bedeutung der Keime in vier Klassen eingeteilt. Klinisch bedeutend sind 3MRGN, 4MRGN und 2MRGN NeoPÄD. Kritisch sind Infektionen mit Keimen der Klasse 4MRGN. Die Mortalität liegt hier bei 50%.
Die Bioscientia hat sich mit ihrer besonderen Kompetenz auf dem Feld der Hygiene und der mikrobiologischen Diagnostik auf dieses Thema spezialisiert. Wir verfügen über ausgebildete Experten zu allen Fragestellungen rund um MRGN und vereinen die nötige Kompetenz zur Lösung des MRGN-Problems in einer Hand:
- Der Bioscientia MRGN-Screen bietet
- in der überwiegenden Mehrzahl der Fälle ein negatives Ergebnis bereits 24 Stunden nach Ankunft der Probe im Labor. MRGN sind sicher ausgeschlossen – eine präventive Isolierung kann rasch aufgehoben werden.
- einen gezielten und zuverlässigen Nachweis von Erregern mit MRGN-Phänotyp inkl. Antibiogrammen.
- den zuverlässigen und gezielten Nachweis von 3MRGN, 4MRGN bzw. 2MRGN NeoPäd – inklusive Antibiogramm zur Einleitung gezielter Maßnahmen.
- Hygiene-Hotline für unsere Kunden
- Beratung und Begehung
- Ausbruchsmanagement
Weiterführende Informationen
Die aktuelle Situation diskutiert Prof. Dr. med. Petra Gastmeier vom NRZ für Krankenhaushygiene an der Charite in einer Veröffentlichung im Ärzteblatt. Zur medizinischen Herausforderung kommt noch die Budgetbelastung. Nach aktuellen Zahlen einer Studie des Wissenschaftlichen Instituts der TK (WINEG) verursacht eine MRE-Infektion durchschnittlich Kosten in Höhe von € 17.500.
Wie funktioniert der Bioscientia MRGN-Screen?
Relativer Anteil 3-MRGN und 4-MRGN im Bioscientia Labor Ingelheim 2021

Erläuterung: Nur 1 Erregernachweis pro Patient, für max. 90 Tage. Alle Fachbereiche, alle Stationen. Tabelle beinhaltet klinische Isolate und Screening-Ergebnisse.
Bekanntmachung:
Hygienemaßnahmen bei Infektionen oder Besiedlung mit multiresistenten gramnegativen Stäbchen. Empfehlung der Kommission für Krankenhaushygiene und Infektionsprävention (KRINKO) beim Robert Koch-Institut (RKI), Bundesgesundheitsblatt 2012, 55:1311–1354, DOI 10.1007/s00103-012-1549-5, © Springer-Verlag 2012
Bekanntmachung:
Mitteilung der Kommission für Krankenhaushygiene und Infektionsprävention (KRINKO). Praktische Umsetzung sowie krankenhaushygienische und infektionspräventive Konsequenzen des mikrobiellen Kolonisationsscreenings bei intensivmedizinisch behandelten Früh- und Neugeborenen. Ergänzende Empfehlung der KRINKO beim Robert Koch-Institut, Berlin, zur Implementierung der Empfehlungen zur Prävention nosokomialer Infektionenbei neonatologischen Intensivpflegepatienten mit einem Geburtsgewicht unter 1.500 g aus dem Jahr 2007 und 2012. (Epidemiologisches Bulletin 42/2013)